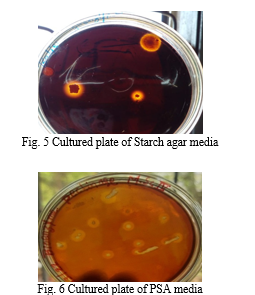

Ijraset Journal For Research in Applied Science and Engineering Technology
Authors: Nikita Dewangan, Baljeet Kaur , Neetu Das, Pragya Kulkarni
DOI Link: https://doi.org/10.22214/ijraset.2022.45641
Certificate: View Certificate
Bioenzyme is produced by the fermentation process of citrus fruit peels, water and jaggery. It is an effective alternative to harsh chemicals such are phenyl, detergent and bleach which are commonly used as a cleaning agent. Excessive usage of harmful chemical product causing degradation of our ecosystem and the objective is to treat pond water using bioenzyme because water contain many chemical from household detergents. The present work comprises screening and isolation of amylolytic and pectinolytic bacteria from indigenously prepared bioenzyme. The starch agar plate and PSA media was used to screen bacteria. Morphological and biochemical characteristics of the screened isolate were tentative identified as Basillus sp. and determined their enzyme activity by DNS method. The enzyme activity of both amylase and pectinase producing bacteria are ranged from 229.5 µmole/min to 936.42 µmole/min and analysis of parameter like BOD for pond water treatment. Different conc. of bioenzyme used for treatment. After treating pond water with it, there was substantial change in BOD value from 44mg/lit to 12mg/lit. It means BOD levels reached permissible level after the treatment.
I. INTRODUCTION
The Enzyme are biological catalyst and also called as biocatalyst that speed up reaction in the living organism and can be pulled out from cell and then used to catalyst a wide range of commercially important processes. Such as production of sweetening agent, modification of antibiotic also used in washing powder and various cleaning agents. [1]
A. Bioenzyme
Bioenzymes are organic compound produced by fermentation of fruit peels in the presence of water and jaggery. These organic substance are capable of the breaking down of chemical and other organic waste thus helping us in removing stanis odour, getting rid of the other harmful microbes.
Bioenzyme is an effective alternative to harsh chemical like detergents which are generally used in households as cleaner for toilet, bathrooms and other surface. Bioenzyme helps to reduce certain waste materials and turn into a useful substance to the society is economically and cheaply available and the end product can be completely useful. [2] [3]
B. Amylase
Amylase is an extracellular, glycoside enzyme that catalyzes the hydrolysis of complex sugar such as starch into subsequent simple sugar molecules. Amylase enzyme can be produced by microorganism especially amylolytic microbes such as Bacillus subtillis, B. aureus, B. azotoformans etc.[4]
C. Pectinase
Pectinase there are various enzymes which are produced naturally by living organisms and more specifically by microorganism which are used for enzyme production.
Pectinase are heterogenous enzyme that hydrolase pectin substance and mostly present in bacteria fungi and higher plants. Pectinolytic bacteria are Erwinia sp., Pseudomonas fluorescens, B. licheniformis, B. cereus. [5][6]
II. MATERIALS & METHODS
We first have to make bioenzyme in this experiment from which amylolytic and pectinolytic bacteria will be isolated and then use that bioenzyme as a cleaner in pond water treatment.
A. Bioenzyme Preparation
We were prepared the bioenzyme by taking the 1:3:10 ratio. In this ratio the 1 part of jaggery, 3 parts of citrus peels and 10 parts of water. After that, we kept it for fermentation for 3 months in an airtight container. In the process of 3 months, in the first month gases generated which were allowed to evolved and later two months kept in the airtight container for further fermentation of the citrus peels. After that the enzyme will be ready for use. [7]
B. Isolation & Screening of Amylolytic and Pectinolytic Bacteria from Bioenzyme
Isolation of amylolytic bacteria from bioenzymes was done by streak plate method through starch agar media and their primary and secondary screening were also done by streak plate method in starch agar plate. After 24 hrs. incubation 37ºC, iodine solution was flooded in the plates then observed the clear zone obtained around the bacterial colony.[8]
Same as, Isolation of pectinolytic bacteria from bioenzyme was done by streak plate method in PSA (Pectinase Screening Agar) media and their primary screening was also done by Streak plate method in PSA media and secondary screening was done by well method in PSA media. After 24 hrs. incubation at 37ºC of this petriplate, iodine solution was flooded in the plate and observed the clear zone around the bacterial colonies.[9][10]
C. Identification of Amylolytic and Pectinolytic Bacteria
The Bacterial isolates with prominent zones of clearance was processes for the determination of morphology, Gram characteristic, Citrate utilization, Methyl Red test, VP test , Indole test, Catalase test and Oxidase test.[11][12]
D. Production of Crude Amylase and Pectinase Enzyme
Isolates with highest clear zone in starch agar media and PSA media were incubate in starch broth and pectinase broth respectively at 37ºC for 3 days and after incubation the media from each flasks were centrifuged at 10000 rpm for 15min. And crude amylase and pectinase enzyme were obtained.[13]
E. Determination of Enzyme Activity
Enzyme activity was measured by the estimation of the amount of product produced through the DNS method. Taken 1 test tube and added reaction mixture which consisted for the determination of amylase activity, 1% substrate(0.1gm starch dissolved in 100ml of distilled water) 1ml and 1ml of crude enzyme and for the determination of pectinase activity reaction mixture which consisted of substrate 1%( 0.1gm pectin dissolved in 100ml of Distilled water) 1ml and 1ml of crude enzyme. These mixture were incubated at 37ºC for 30min in incubator. Later 1ml of DNS reagent was added to the test tube and kept in boiling water bath for 10min, solution turned to reddish colour. A blank was also prepared in the same way and used distilled water in place of enzyme for blank. The absorbance was read at 550nm using spectrophotometer and a graph was drawn by plotting absorbance against conc. [14]
Estimate the conc. of reducing sugar in crude enzyme from the slope of graph and calculate the enzyme activity from formula. [15]

F. Application of Bioenzyme for Pond Water Treatment
Use of bioenzyme is an effective method of treatment of pond water. To investigate the effectiveness of bioenzyme application as an alternative method in pond water treatment by measuring BOD before and after application of enzyme specially selected bacteria release enzyme that liquefy and then literally accelerate the digestion process of organic content present in pond water.[16]
To estimation of DO is the most important step in BOD calculation of water is usually estimated by winkler’s method which is titrimetric method and calculate the amount of DO by using following formula- [17][18]

Where, V = Volume of Water Sample use for Titration
N = Normality of Titrate (0.025N)
v = Amount of Sodium thiosulfate
8 = Constant value of Equivalent
BOD = Biological oxygen demand
D1 = Initial dissolved oxygen(DO) , D2 = Final dissolved oxygen
III. RESULT AND DISCUSSION
Bioenzyme was produced by the fermentation process. The solution was filtered after 3 months to obtain bioenzyme. That obtained bioenzyme solution was light brownish yellow coloured. Total 830ml of bioenzyme solution was prepared. From the isolation and screening of amylolytic bacteria there were only single type of bacterial colonies grown on the starch agar plate after incubation and clear zone was observed after treat with gram’s iodine solution and their diameter was 15mm. and from the isolation and screening of pectinolytic bacteria, there was also only single type of bacterial colonies grown on the PSA media plate and their observed clear zone diameter was 20mm. The identification of the selected bacterial strains were done on the basis of morphological and biological characteristics. On the basis of morphology and biochemical tests, the selected amylolytic bacterial strain was identified as Bacillus sp. and pectinolytic bacterial strain was also identified as Bacillus sp.. The details of biochemical characteristics of pectinolytic and amylolytic are given in table:2
The Determined amylase and pectinase enzyme activity by DNS method in which reducing sugar were measured by adding 3,5 Dnitrosalicylic acid reagent, using maltose, galacturonic acid respectively as standard and the enzyme activity of crude amylase, pectinase enzyme were calculated as 229.5µmole/min, 936.42µmole/min respectively.
Application: Effect of Bioenzyme in the Treatment of Pond Water
This study is carried out on pond water, upon treating pond water with bioenzyme there was significant change in BOD value of the water. Characteristics of pond water before and after treatment with bioenzyme were analyzed and indicated in table5. It was proven that bioenzyme has a promising effect in the treating of pond water as the reduction in level of BOD 44mg/lit to 12mg/lit. Table No. 1 Bioenzyme Production

IV. ACKNOWLEDGEMENT
The authors are thankful to the Govt. V.Y.T. Pg. Autonomous College, Durg, Chhattisgarh for providing support and lab facilities for this research.
The whole study concluded that the enzymes are biological catalysts. In the present study bioenzyme produced using citrus fruit waste after potential solution to treat pond water in ecofriendly way. Result show that bioenzyme accelerate the digestion process of organic content present in pond water. This show that the water to be cleaner after the treatment. Bioenzyme is a multipurpose solution for domestic and agriculture application and it is organic it won’t have any side effects. Compare to other method this can be an easy and cost effective method and reduce the use of synthetic chemical that are toxic to human health and the environment. “Conversion of Wastes into Value Added Products is Potentially Profitable besides Creating a Clean Environment.”
[1] Dhavale V., Shimpi T.,Koli V.,Kamble R., Patil S., Bioenzymes from Organic Waste, Journal of Emerging Technologies and Innovative Research,Vol.7, 196-199,Aug.2020 [2] Agarwal P., Kaur S., Effect of Bioenzyme Stabilization on Unconfined Compressive Strength of Expansive Soil, International Journal of Research in Engineering & Technology, Vol. 3, pg. 30-33, May- 2014. [3] Penmatsa B., Chandrashekhar D., Diwakar B., Nagalakshmi T., Effect of Bio Enzyme in The Treatment Of Freshwater Bodies, International Journal Of Recent Technology & Engineering,ISSN: 2277-3878, Vol. 8, June 2019. [4] Madhav K.,Verma S.,Tanta R., Isolation of Amylase Producing Bacillus Species from Soil Sample of Different Region in Dehradun Check the Effect of pH and Temperature on their Amylase Activity, Journal of Pharmaceuticals and Biomedical Science, Vol.12 Issue 12, 2011. [5] Haile S., Ayele A., Pectinase From Microorganisms and Its Industrial Applications, The Scientific World Journal Article Id 1881305 vol. 2022 pg. 15. [6] Arsad H., Ali A., Kanwali A., Tariq H., Isolation and Characterization of Pectinase Producing Bacillus subtilis From Agro Waste Dump Yards of Lahore, Research Journal of Biotechnology, Vol. 14, pg. 9 [7] Aartheeswari S., Kirthiga B., Production Of An Ecofriendly Enzyme Biocleaner From Fruit Wastage, Internatinal Journal For Research In Engineering Application & Management, ISSN: 2454-9150, Vol.06, Mar 2021. [8] Rayhan Islam Md.,Kumer O., Saimoon Rahman Md, Billah M, Shahedur Rahman M. and Zohora S.,Screening of ?-Amylase Producing Bacteria from Tannery Wastes of Hazaribag, Bangladesh Jahangirnagar University J. Biol. Sci. 5(2): 1-10, 2016 (December) [9] Oumer O., Abate D, Screening and Molecular Identification of Pectinase Producing Microbes From Cofee Pulp, Biomed Research International, vol. 2018, pg. 7.ol. 4, No. 2, pp,12-26, 2018. [10] Aaisha G. A., Barate D., Isolation and Identification of Pectinolytic Bacteria From Soil Samples of Akola Region, india, International Journal Of Current Microbiology & Applied Sciences, ISSN: 2319-7706, Vol.5, No. 1, pp514-521, 2016. [11] Becerra SC., Daniel C., Carlos JS., Robert J., David M, An Optimized Staining Technique for the Detection of Gram Positive and Gram Negative Bacteria within Tissue, BioMed Central Research Notes,(2016) 9:216 [12] Hamdani S., Asstiyani N., Astriany D., Singgih M., Ibrahim S., Isolation and Identification of Proteolytic Bacteria From Pig Sludge and Protease Activity Determination, International Conference on Green Agro Industry and Bioeconomy, 2019 2-96, Dec. 2019. [13] Rehman H., Siddique N., Aman A, Nawaz M, Baloch A, Qudar S. Morphological and Molecular Based Identification of Pectinase Producing Bacillus licheniformis From Rotten Vegetable, Journal of Genetic Engineering and Biotechnology, 2015 [14] Miller G. L., Use of Dintrosalicylic Acid Reagent For Determination of Reducing Sugar, Analytical Chemistry, 1959, 31(3): 426-428. [15] Kavuthodi B., Sebastian D., Review on Bacterial Production of Alkaline Pectinase with Special Emphasis on Bacillus sp., Bioscience Bitechnology Research Communications, 11[1], 18-30, 2018. [16] Gosh S., Paul M., Raha A., Mukherhee P., Bagchi A., Statistical Evaluational of Biochemical Oxygen Demand of River Water, Advance Pharmaceutical Journal, 2018, 3(4), 118-121. [17] Langdon C., Determination of Dissolved Oxygen in Seawater by Winkler Titration Using the Amperometric Technique, The GO-SHIP Repeat Hydrography Manual, Report No. 14, Version 1, pg.1-17, 2010. [18] Aneja K., Experiments in Microbiology, Plant Pathology & Biotechnology, Apr. 2018
Copyright © 2022 Nikita Dewangan, Baljeet Kaur , Neetu Das, Pragya Kulkarni. This is an open access article distributed under the Creative Commons Attribution License, which permits unrestricted use, distribution, and reproduction in any medium, provided the original work is properly cited.
Paper Id : IJRASET45641
Publish Date : 2022-07-14
ISSN : 2321-9653
Publisher Name : IJRASET
DOI Link : Click Here
Submit Paper Online
